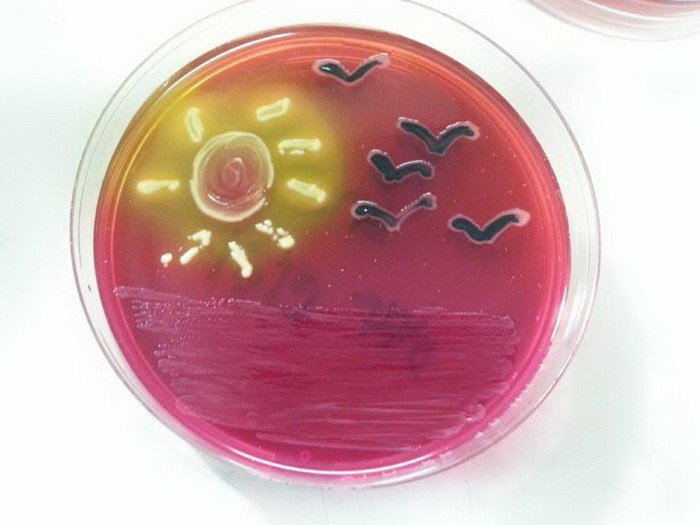

Питательные среды для бактерий: что нужно знать?

Раздел: Фотомир